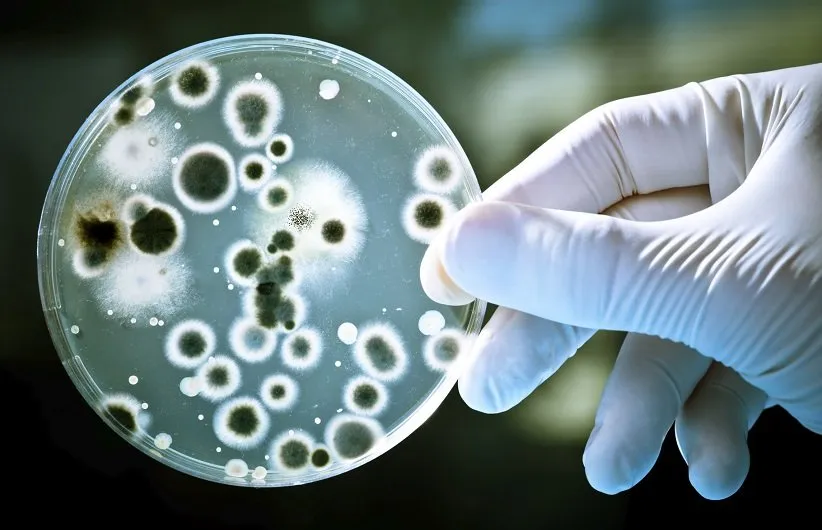
باکتری‌ها همیشه خطرناکند

۱۹ باور نادرست رایج دربارهی سلامتی که شما را شوکه میکنند
تلاش برای تغذیه و تناسب اندام به اندازهی کافی چالش برانگیز است و دردسر دارد. اکنون گمان کنید باید همیشه حواستان به بسیاری از نکتههای سلامتی و باورهایی هم باشد که خبر از به خطر افتادن جانتان میدهند!
کافیست سری به اینترنت بزنید یا با آشنایان خود گفتوگو کنید تا با نکتههای گوناگونی برای داشتن سلامتی روبهرو شوید. ولی آیا این باورها همیشه درستاند؟
در این نوشته به بررسی همین موضوع میپردازیم. در ادامه با 19 باور نادرست دربارهی سلامتی که ممکن است همیشه به گوشتان بخورند، همراه باشید.
1. باید روزی 8 لیوان آب بخورید

آیا بدن شما با مصرف 8 لیوان آب در روز کارکرد بهتری خواهد داشت؟ نه، همیشه هم اینگونه نیست. نیاز هرکس به مایعات با دیگران ناهمسان است. چیزهایی مانند آبوهوا، دما و رطوبت، جثه، جنسیت و سطح فعالیت بدنی تأثیر فراوانی روی میزان آب مصرفی در روز میگذارند.
گاهی اوقات این باور دارای جزئیات بیشتری است. برای نمونه، برخی میگویند نوشیدن 8 لیوان آب به کاهش وزن کمک میکند. ولی در یک پژوهش با بررسی 38 شخص که اضافه وزن داشتند؛ به هیچ نتیجهی مثبتی نرسیدند. برخی دیگر هم ادعا میکنند نوشیدن آب بیشتر از آنکه تشنه باشید، میتواند به آبرسانی و داشتن پوستی نرم و صافتر، کاهش سردرد و دفع سموم بیشتر از کلیهها منجر شود. همهی این باورها بررسی شده و نادرست از آب درآمدهاند. بنابراین، مصرف آب با توجه به میزان تشنگی، بهترین گزینه برای بسیاری از مردم خواهد بود.
2. تخممرغ برای قلب ضرر دارد

تخممرغ در مقایسه با سایر مواد غذایی، سرشار از کلسترول است. کلسترول موجود در خون ارتباط بسیار بالایی با بیماریها و حملات قلبی دارد. بنابراین، زیادهروی در مصرف تخممرغ میتواند برای قلب ضرر داشته باشد، اینطور نیست؟ اگرچه این باور منطقی به نظر میرسد، ولی پژوهشها آن را نمیپذیرند.
مصرف کموبیش یک تخممرغ در روز برای کسانی که سطح کلسترول طبیعی دارند، هرگز خطر ابتلا به بیماریهای قلبی-عروقی را که میتوانند به منجر به حملهی قلبی شوند، افزایش نمیدهد. این میتواند به دلیل ویژگیهای سودمند و محافظ تخممرغ برای قلب باشد که کلسترول را خنثی میکنند. همچنین شاید به این دلیل باشد که خوردن کلسترول ارتباط ضعیفی با افزایش کلسترول خون دارد. در هر صورت، نمیتوان ثابت کرد تخممرغ برای قلب ضرر دارد.
3. ضدعرقها منجر به سرطان یا آلزایمر میشوند

بیش از 40 سال پیش، زنگ خطر دربارهی ارتباط ضدعرقها و زوال عقل به صدا درآمد. پژوهشگران با نسبت بالاتری از آلومینیوم در مغز بیماران مبتلا به آلزایمر روبهرو شدند. این نگرانی وجود داشت که آلومینیومی که مجاری عرق شما را به طور موقت میبندد، میتواند مشکلات عصبی را افزایش دهد. ولی با گذشت زمان، هیچ مدرکی برای اثبات این موضوع پیدا نشد. به نظر نمیرسد آلومینیوم از طریق پوست جذب شود. یعنی آلومینیوم موجود در مغز بیماران آلزایمری، میتواند نتیجهی این بیماری باشد، نه علت به وجود آمدن آن!
بسیاری هم بر این باور بودند که ضدعرقها منجر به حبس شدن سموم در بدن میشوند و نمیگذارند از طریق عرق کردن دفع شوند. ولی این ضدعرقها تنها از خروج عرق و نمک بدن جلوگیری میکنند و کاری به سموم ندارند. زیرا سموم معمولا از طریق ادرار و مدفوع خارج میشوند.
4. سرماخوردگی به دلیل هوای سرد

شاید این را همیشه از مادرتان شنیده باشید، «با موهای خیس نرو بیرون، سرما میخوری!»
با همهی احترامی که برای مادران قائلیم، این موضوع هیچ ربطی به سرماخوردگی ندارد. اگر در هوای سرد بیرون بروید، چه موها و لباسهایتان خیس باشند چه نباشند، هیچ خطری شما را برای سرماخوردگی تهدید نمیکند. در واقع سرماخوردگی ربطی به آبوهوا ندارد و به دست ویروسها منتشر میشود و شما را مریض میکند.
اکنون پرسشی که پیش میآید، این است که پس چرا سرماخوردگی و آنفولانزا در زمستان شایعتر است؟ این سخن درستی است که چیزی به نام «فصل سرماخوردگی» و «فصل آنفولانزا» وجود دارد و کموبیش از ماه مهر تا اسفند ادامه پیدا میکند. ولی علت بنیادین آن میتواند به خانهنشینی مردم به دلیل سرد بودن محیط بیرون از خانه برگردد. یعنی هنگامی که مردم به دلیل سرما خانهنشین میشوند، شانس پخش شدن ویروس سرماخوردگی، از آنجا که مردم به یکدیگر نزدیکتر هستند، بالاتر میرود.
5. همه به مولتیویتامین نیاز دارند

ویتامینها به طور کلی سالم به نظر میرسند. آنها سرشار از مواد مغذی هستند که باعث میشوند بدن ما با بیماریهای گوناگون مبارزه کند، سلولها رشد کنند و اعصاب بدن هم کارکرد درستی داشته باشند. پس مصرف روزانهی ویتامینها سودمند به نظر میرسد، مگر نه؟
باید بگوییم خیر، اینگونه نیست. ویتامینها بیخطر هم نیستند. برای نمونه، مصرف مکملهای بتاکاروتن و ویتامینهای A و E با افزایش میزان مرگ همراه است. افزون بر این، بزرگسالانی که تغذیه مناسب دارند، هیچ سودی از این ویتامینهای اضافی نمیبرند. بیشتر آمریکاییها همهی ویتامینهای مورد نیازشان را از طریق غذا خوردن تأمین میکنند و مصرف اضافی این ویتامین از طریق مکملها هیچ کمکی بهشان نمیکند.
بنا بر برخی پژوهشها، مصرف مکملهای ویتامین تنها دور ریختن پول است. ولی باید یادتان باشد برخی از مردم به این مکملها نیاز دارند. برای نمونه، پزشکان پیشنهاد میکنند زنان باردار و کسانی که دارای برخی بیماریها هستند یا مشکلات تغذیهای دارند، باید به سراغ مکملها بروند.
6. صبحانه میتواند به کاهش وزن کمک کند

احتمالا شنیدهاید که میگویند نخوردن صبحانه منجر به دشوارتر شدن کاهش وزن میشود. این باور درست نیست و مدرک قطعی برای اثبات آن وجود ندارد.
این باور ادعا دارد اگر صبحانه بخورید، در درازای روز کمتر گرسنه خواهید بود و بنابراین کالری کمتری وارد بدنتان خواهید کرد. همچنین شب هنگام هم به دلیل فعالیت پایین بدن، غذای کمتری مصرف خواهید کرد. پژوهشها نشان دادهاند که «زمان» دریافت کالری تأثیری روی کاهش یا افزایش وزن ندارد. به این معنا که برای بدن شما میزان کالری مهم است، نه اینکه چه زمانی از روز آن را دریافت کنید.
اگرچه، یک مطالعه وجود دارد که اهمیت صبحانه خوردن را نشان میدهد. پژوهشگران مشاهده کردهاند با نخوردن صبحانه دچار افزایش التهاب در خون خواهید شد. با وجود این، هیچ فایدهی قطعی برای صبحانه خوردن به ثبت نرسیده است.
7. مخاط سبز نشاندهندهی عفونت و بیماری است

بسیاری از مردم بر این باورند که اگر عطسه کرده و بینی خود را تمیز کنند، و با مخاط سبز روبهرو شوند، حتما باید به سراغ پزشک و داروهای آنتیبیوتیک بروند. آیا این کار ضرورت دارد؟ نه، اینگونه نیست!
شما هنگامی که یک آنتیبیوتیک میخورید، به بدن خود کمک میکنید تا با یک عفونت باکتریایی، و تنها همین عفونت باکتریایی، مبارزه کند. ولی بیشتر سرماخوردگیها ناشی از ویروسها هستند. آنتیبیوتیکها در برابر ویروسها کاملا بیفایده به شمار میروند. افزون بر این، رنگ سبز مخاط هم دلیل بر وجود عفونت باکتریایی نیست، زیرا ویروسها هم میتوانند مخاط سبز به وجود بیاورند.
اکنون یادتان باشد تنها گزینههای زیر نشانه از عفونت باکتریایی در بدن هستند و نیاز به آنتیبیوتیک دارند:
- تب بالای شما بهبود پیدا نمیکند.
- مخاط شما ضخیم و سفید مانند چرک به نظر میرسد.
- بیش از 10 روز است که مریض هستید.
- بیماری شما شدید است و با درمانهای استاندارد سرماخوردگی بهتر نمیشود.
8. شکر و کودکانی که خانه را روی سرشان میگذارند!

شب به مهمانی رفتهاید یا در خانهتان مهمانی گرفتهاید و به همراه فرزندانتان حسابی با انواع شیرینیها سرگرم بودهاید. اکنون کودکانتان خانه را روی سرشان گذاشتهاند و هنگام خواب هم همچنان فعال هستند.
بسیاری از پدرها و مادرها این موضوع را به مصرف شکر ربط میدهند. ولی اینگونه که پیدا است، شکر هیچ نقشی در بیشفعالی کودکان ندارد. این باور به سالها پیش بازمیگردد. در دههی 70 میلادی، رژیمی به نام «فینگولد» وجود داشت که به پدرها و مادرها برای مصرف شکر کودکانشان هشدار میداد. این رژیم بعدها بیاعتبار شد و کاملا از یاد رفت. ولی تأثیر و باور نادرست آن همچنان در ذهن خانوادهها باقی مانده است.
پژوهشگران هیچ تفاوتی در مصرف کردن یا نکردن شکر پیدا نکردهاند. آنها با بررسی کودکانی که شکر میخوردند، هیچ دگرگونی در رفتار یا میزان انرژی و بیشفعالی آنها مشاهده نکردند.
9. توالتها مریضی را به شما انتقال میدهند

ممکن است خیلی طرفدار استفاده از توالتهای عمومی نباشید، ولی در بیشتر اوقات، هیچ جای نگرانی برای ابتلا به بیماریها وجود ندارد. برای پی بردن به این موضوع، باید یادآوری کنیم میکروبهای بیماریزا همهجا هستند؛ از صفحه کلید گرفته، تا دستگیرهی در، پول یا حتی گوشیهای همراهتان!
درست است که این میکروبها در توالتها هم هستند، ولی شما بیشتر از کدام اینها استفاده میکنید؟ توالت عمومی یا گوشی همراه؟ کدام را همیشه در دست دارید و نزدیک صورتتان میگیرید؟ و از همه جالبتر، به نظرتان کدام یک از اینها همواره تمیز و شستوشو داده میشوند؟ در مقایسه با سایر اشیایی که روزانه لمس میکنید، توالتها منبع قابلتوجهای برای پیدایش بیماریها به شمار نمیروند.
به طور کلی، اگر هم میکروب بیماریزا در توالت وجود داشته باشد، شما تنها با شستن دستانتان آنها را از بین خواهید برد. بنابراین، هرگز نگران این باور نادرست نباشید.
10. قولنج شکستن منجر به آرتروز میشود

شاید صدای تق تق کردن انگشتانتان برای دیگران آزاردهنده باشد، ولی هیچ نتیجهی منفی دیگری ندارد و منجر به آرتروز هم نمیشود. این صداها، تنها سروصدای ناشی از ترکیدن حبابهای درون مایع مفصل شما است.
اگرچه، حواستان باشد این عادت هنوز هم کاملا بیخطر نیست. اگر به طور مرتب قولنج انگشتانتان را بشکنید، خود را در معرض ورم کردن دست و انگشتها قرار خواهید داد. افزون بر این، کسانی که عاشق این کار هستند ممکن است دچار ضعف دست و پایین آمدن قدرت نگه داشتن اشیا شوند.
11. غذاهای طبیعی همیشه بهترین گزینهاند

مردم، طرفدار غذاهای طبیعی هستند و صنایع غذایی هم این را بهخوبی میدانند. ممکن است در برخی فروشگاهها خوراکیهایی را مانند چیپس، بستنی و نوشابه پیدا کنید که برچسب «ارگانیک» یا «طبیعی» رویشان قرار دارد. آیا این برچسب بدین معنا است که آنها سالم هستند؟ این یکی دیگر از باورهای نادرست است که باید آن را بررسی کنیم.
مشکلی که وجود دارد این است که نمک و بسیاری از سموم هم طبیعی هستند. آیا آنها هم سالم به شمار میروند؟ مسلما استفاده از واژهی «طبیعی» برای توصیف یک مادهی غذایی، نشاندهندهی سالم بودن آن نیست. برای اینکه پی ببرید آیا یک خوراکی سالم است یا نه، باید به برچسب ارزش غذایی آن نگاه کنید. چیزهایی مانند میزان چربی اشباع، قند و دیگر منابع کالری محض هستند که سالم بودن یک خوراکی را نشان میدهند. و غذاهای طبیعی و ارگانیک هم میتوانند سرشار از این مواد باشند.
12. واکسنها خطرناکند

امروزه واکسنها مخالفان بسیار فراوانی دارند. ترس از واکسن منجر شده بسیاری از پدرها و مادرها ترجیح دهند کودکانشان را واکسن نکنند. آیا این ترس منطقی است؟ آیا واکسنها میتوانند به شما آسیب بزنند؟
واکسنها، درست مانند هر داروی دیگری، میتوانند عوارض جانبی داشته باشند. البته این عوارض به طور معمول جزئی هستند؛ چیزهایی مانند جوشهای ریز و قرمز در پیرامون محل واکسن، و گاهی هم آلرژیهایی که به وجود میآیند و پزشکان و پرستاران همیشه حواسشان به آنها است. بنابراین، باید تا چند روز پس از واکسن به نشانههای آلرژی دقت داشته باشید و در صورت مشاهده، به پزشک مراجعه کنید.
این عوارض جانبی به اندازهای اندک هستند که نمیتوانند فواید واکسنها را تحت شعاع قرار دهند. واکسنها با بیماریهای بسیار خطرناکی مبارزه میکنند؛ بیماریهایی مانند فلج اطفال، سرخک و سیاه سرفه. ولی امروزه به دلیل ترس از واکسن، بسیاری از بیماریها در حال افزایش هستند. بنابراین، باید ترس از واکسن را کنار بگذارید و این باور نادرست را از یاد ببرید.
13. مایکروویو و گوشیهای هوشمند سرطانزا هستند

چه چیزی میان مایکروویو و گوشیهای هوشمند مشترک است؟ هردوی آنها انرژی ساطع میکنند که به آن تشعشع یا پرتوافشانی هم میگویند. اکنون این پرتوها چه ربطی به سرطان دارند؟ پاسخ کوتاه و مفید، «هیچ ربطی ندارند!»
برخی از اختراعاتی که انرژی ساطع میکنند، مانند دستگاههای اشعه ایکس، میتوانند به DNA آسیب برسانند و خطر ابتلا به سرطان را افزایش دهند. و به همین ترتیب اشعهی ماورای بنفش خورشید هم میتواند منجر به سرطان پوست شود. ولی این بدین معنی نیست که همهی چیزهایی که انرژی ساطع میکنند، میتوانند به DNA شما آسیب برسانند. حتی بدن خود شما هم برای ایجاد گرما انرژی ساطع میکند!
انرژیها شدتهای گوناگونی دارند. انرژی گوشیهای همراه از گونهی سبک است و به همین دلیل نمیتواند شما را به سرطان مبتلا کند. به طور کلی، هیچ مدرکی برای اثبات این موضوع وجود ندارد. با وجود این، همچنان به پژوهشهای بیشتری نیاز است.
14. باکتریها همیشه خطرناکند
آیا با شنیدن نام باکتریها حس بدی پیدا میکنید؟ این موجودات ریز و تکسلولی، مسئول بسیاری از بیماریهای بیمناک مانند سل، سفلیس و وبا هستند. بسیاری از مردم بر این باورند که باکتریها همگی خطرناکند. ولی نکتهی جالب این است که شمار باکتریهای موجود در بدن شما، از سلولهای ساختاریتان بیشتر است!
خطرناک بودن یا نبودن باکتریها، به نوع آنها بستگی دارد. با اینکه برخی باکتریهای خطرناک و عفونی وجود دارند و باید مراقبشان باشید، باکتریهای بیخطر یا خنثی هم وجود دارند که برای زندگی ما مفید به شمار میروند. حتی ممکن است گاهی با نبود این باکتریها یا از میان بردنشان، به بدن خود آسیب هم بزنیم.
باکتریهای مفید فراوانی وجود دارند که به ما برای هضم غذا و کارکرد درست بدنمان کمک میکنند. بنابراین، همهی آنها هم خطرناک نیستند.
15. رژیمهای غذایی بر اساس گروه خونی، کارآمد هستند

آیا گروه خونی شما میتواند راهکاری برای کاهش وزن باشد؟
در سال 1996 یک کتاب رژیم غذایی چاپ شد و ادعا کرد که چنین چیزی ممکن است. چندین رژیم غذایی بسته به گروه خونی ABO در این کتاب پیشنهاد شده بود و خبر از تأثیر آن روی کاهش وزن میداد.
پژوهشگران این رژیمها را بررسی کردند و به این نتیجه رسیدند که اگرچه نتایج مثبتی برای سلامتی در پی دارند، ولی هیچ ربطی به گروه خونی مردم ندارند. برای نمونه، کسانی که از رژیم غذایی مخصوص گروه خونی O استفاده کردند، دارای یک رژیم کمکربوهیدرات بودند که فواید آن برای سایر گروه خونیها هم در دسترس بود. از آنجایی که گروه خونی مردم نقشی در این رژیمهای غذایی نداشت، پژوهشگران این باور را رد کردند و رژیمهای گروه خونی به یک باور نادرست دگرگون شدند.
16. محصولات سمزدا میتوانند بدنتان را پاکسازی کنند

آیا بدن شما برای دفع سموم به یک پاککننده نیاز دارد؟ به نظر میرسد ایدهی جالبی باشد. اگر بتوانید بدن خود را از شر مواد شیمیایی و سموم رها کنید، میتوانید انرژی بیشتری داشته باشید، بهتر بخوابید و تمرکز ذهنتیتان هم بالا برود. افزون بر این، دانستن اینکه بدن شما از دست این سموم راحت شده و ممکن است سلامتتان هم بهبود پیدا کند، بدون شک رضایتبخش خواهد بود. پرسشی که وجود دارد این است که آیا این سمزدایی تأثیرگذار است؟
برای اینکه پزشکان پی ببرند آیا سمزدایی تأثیرگذار است، به دانستن دو چیز نیاز دارند. نخست اینکه باید بدانند چه سمومی از بدن خارج میشوند، دوم هم اینکه چگونه این رویداد رخ میدهد. در یک پژوهش، 15 محصول سمزدایی بررسی شدند. بیشتر این محصولات، تنها پاککنندههای ساده بودند و حتی شرکتهای سازنده هم چیزی دربارهی چگونگی سمزدایی و اینکه چه سمومی را دفع میکنند، نمیدانستند.
بنابراین، این سمزدایی تنها یک ترفند تبلیغاتی به شمار میرود و پیش از خرید این محصولات باید حسابی حواستان را جمع کنید!
17. برخی محصولات میتوانند سیستم ایمنی بدنتان را تقویت کنند

بسیاری از محصولات ادعا میکنند که میتوانند سیستم ایمنی شما را بهبود دهند یا تقویت کنند. ول معمولا هیچ اطلاعی دربارهی چگونگی این کار در اختیارتان قرار نمیدهند. چیزی که باید از خودتان بپرسید، این است که دقیقا چه بخشی از سیستم ایمنی را تقویت میکنند؟
سیستم ایمنی دارای یک سری فرایند پیچیده است که شامل پادتنها، پروتئینهای ویژه، بخشهایی از خون (مانند گلبول سفید) و چیزهای فراوان دیگری میشود. هنگامی که یک محصول از تقویت سیستم ایمنی خبر میدهد ولی نمیگوید چگونه، باید بلافاصله به آن شک کنید.
افزون بر این، برخی روشهای تقویت سیستم ایمنی میتوانند خطرناک هم باشند. برای نمونه، یکی از مهمترین کارکردهای سیستم ایمنی، مبارزه با التهاب است. برخی محصولات ممکن است پاسخ بدن نسبت به التهاب را فعال کنند تا سیستم ایمنی فعال و تقویت شود. ولی این میتواند سکتهی مغزی، حملات قلبی و دردسرهای دیگری را برای سلامتی به دنبال داشته باشد.
18. شما تنها از 10 درصد مغزتان استفاده میکنید

اگر تنها از 10 درصد مغزتان استفاده میکنید، پس میتوانید 90 درصد دیگر را دور بریزید و آسیبی نبینید، اینطور نیست؟ طرفداران این باور اعتقاد دارند اگر بتوانید باقی 90 درصد را فعال کنید، میتوانید به تواناییهای شگفتانگیزی دست پیدا کنید که حتی خواباش را هم نمیبینید. ولی مشکلی که وجود دارد این است که این باور از پایه نادرست است!
این باور به آزمایشی روی موشها در دههی 30 میلادی برمیگردد. پژوهشگران با حذف بخشهایی از مغز موشها متوجه شدند آنها همچنان میتوانند برخی فعالیتهای اساسی را انجام دهند. ولی این بررسی دارای محدودیتهای فراوانی بوده و بسیاری از کمبودهای موشها آزمایش نشده است.
این باور نادرست هر چه که باشد، دستکم صحت ندارد. اسکنهای مغزی حاکی از این هستند که مغز شما همیشه فعال و درگیر است. بدون شک برای انجام برخی فعالیتها، ظرفیت مغز افزایش یا کاهش پیدا میکند، ولی دلیل بر این نیست که 90 درصد آن مورد استفاده قرار نگیرد.
19. شنا کردن بلافاصله پس از غذا خوردن منجر به گرفتگی ماهیچهها میشود

پس از خوردن غذا تا کی باید صبر کرده و سپس شنا کنید؟ اگر بخواهید به بسیاری از باورها و توصیهها گوش کنید، احتمالا باید دستکم 100 سال منتظر بمانید. زیرا خیلیها اعتقاد دارند شنا کردن پس از غذا خوردن، منجر به گرفتگی ماهیچهها میشود.
خوشبختانه، برای شناگران جوان هیچ مشکلی به وجود نخواهد آمد و این تنها یک باور نادرست است. ولی اگر هنگام شنا کردن دچار گرفتگی شدید چه؟ شاید شکمِ پر منجر به ایجاد این گرفتگیها نشود، ولی خود شنا کردن میتواند باعث کشیده شدن ماهیچهها یا چنگه شود.
با وجود همهی اینها، گرفتگی ماهیچهها چیز خطرناکی نیست. اگر هنگام شنا به آن دچار شدید، کافی است آرام بمانید و ماهیچهی گرفته را سفت و شل کنید تا گرفتگی از میان برود.
سخن پایانی
اگرچه این باورها تلاش میکنند منطقی به نظر برسند، ولی هیچ مدرکی برای اثبات آنها وجود ندارد.
اکنون که با این باورها آشنا شدید، تلاش کنید آنها را نادیده گرفته و تنها پس از مشورت با متخصصان و پزشکان، برای حفظ سلامتیتان تصمیم بگیرید.
منبع: MedicineNet